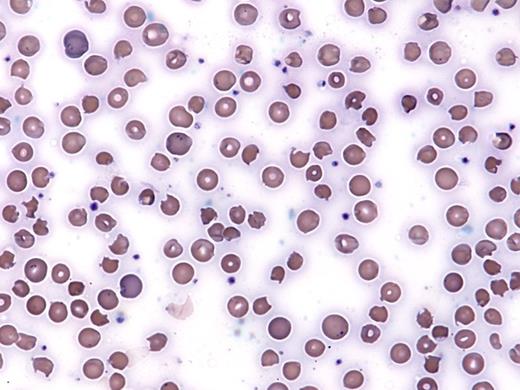
IC Hall 3/3/17. / IC Hall 3/3/17

A 58-year-old Asian woman with a history of inclusion body myositis on high-dose corticosteroids and methotrexate was noted to be hypoxic (oxygen saturation 86% by pulse oximetry) in an outpatient clinic. She had recently been started on dapsone for PCP prophylaxis. Her vital signs were otherwise stable. She reported fatigue, but no cough, fevers, or other symptom concerning for infection. Further laboratory work-up revealed a white blood cell count of 18 × 109/L, hemoglobin of 6.9 g/dL (MCV 106 fL), and platelet count of 182 × 109/L. Reticulocytes made up 8 percent of her red blood cells. Her hemoglobin was 12 g/dL two weeks prior. She reported no history of bleeding. Despite an increasing concentration of supplemental oxygen (up to 15 L/min by facemask), she remained with a saturation of 87 percent. Chest x-ray was clear, and CT pulmonary embolism (PE) protocol did not reveal a PE. A peripheral blood smear was obtained and is shown in the Figure below:
IC Hall 3/3/17
A. ADAMTS13 activity and inhibitor level
B. Glucose-6-Phosphate Dehydrogenase (G6PD) screen
C. Blood methemoglobin level
D. Coombs test
E. DIC panel
Sorry, that was not the preferred response.
Correct!
The patient shows evidence of oxidative changes on the peripheral blood smear, in particular the presence bite cells and Heinz bodies. There are also some microangiopathic changes (e.g. schistocytes) on this smear. The presence of hypoxemia by pulse oximetry that does not respond to increasing oxygen supplementation raises concern for methemoglobinemia. A classic finding in methemoglobinemia is the presence of a “saturation gap” between the saturation measured on pulse oximetry and on co-oximetry testing through arterial blood gas analysis. Pulse oximetry often shows a minimum oxygen saturation of approximately 80 percent even if the patient’s methemoglobin level is 30 percent or more, while the saturation on an arterial blood gas sample (and the often marked difference between the PaO2 and hemoglobin saturation due to the presence of methemoglobin) is more reliable.1
In this case, a serum methemoglobin level returned markedly elevated at 15.3 percent (normal <2%). Ancillary studies provided additional evidence of hemolysis (haptoglobin <8 mg/dL [normal 35-278], LDH 762 U/L [normal <340] and unconjugated bilirubin 2.2 mg/dL [normal <1.0 mg/dL]). A Coombs test was negative. The constellation of Coombs-negative hemolytic anemia with oxidative changes on blood smear and methemoglobin shortly after starting dapsone was highly suggestive of dapsone toxicity. Further tests revealed a normal serum lactate and negative troponin. She did not appear tachypneic or cyanotic. Methylene blue was considered but deferred given her clinical stability. Her methemoglobin level normalized within 36 hours of admission, and her saturation was 97 percent on room air.
Dapsone use is associated with both methemoglobinemia and hemolytic anemia. It is commonly used for treatment and prophylaxis of Pneumocystis jiroveci infection in patients who are intolerant to trimethoprim-sulfamethoxazole. Clinically significant hemolysis and methemoglobinemia occur most commonly in patients receiving therapeutic dosing, but has been reported in patients receiving prophylactic dosing.2 In susceptible patients, dapsone and its hydroxylamine metabolites lead to oxidative stress, which causes hemoglobin denaturation, and ultimately hemolysis. The same oxidative stress also overwhelms the red blood cell’s (RBCs) ability to reduce methemoglobin, resulting in methemoglobinemia. The methemoglobin form of hemoglobin is not able to bind oxygen. This effect is often accentuated in patients with glucose-6-phosphate dehydrogenase (G6PD) deficiency, methemoglobin reductase deficiency, or in patients taking other medications that interact with dapsone. Some level of methemoglobinemia and/or hemolysis occurs frequently in patients treated with dapsone, but is often subclinical. A recent series of patients with hematologic malignancy showed an elevated methemoglobin level in 13 of 34 patients with hematologic malignancies treated with dapsone, with four patients experiencing symptomatic methemoglobinemia.3
G6PD is the main defense of the RBC against oxidative stress by reducing nicotinamide adenine dinucleotide phosphate (NADP) to NADPH. The patient in this case had a G6PD qualitative screen measured prior to starting the medication, and this was normal. G6PD screening tests reflect the amount of G6PD in a patient’s RBCs. This level naturally decreases in a RBC over time. In an acute hemolytic episode, the RBCs with the lowest concentration of G6PD will be destroyed and the screen can result as a false negative. In the setting of acute hemolysis, quantitative or genetic testing may be more useful in diagnosis than the qualitative assay.
ADAMTS13 studies would be useful to aid in the diagnosis of thrombotic thrombocytopenic purpura, but the normal platelet count makes this less likely. The Coombs test would be most useful in supporting a diagnosis of autoimmune hemolytic anemia, but in this case the lack of spherocytes and associated hypoxia make this less likely. A disseminated intravascular coagulation panel would be reasonable given the findings on the peripheral smear but would not directly lead to the most likely diagnosis.
References
References
The authors indicated no relevant conflicts of interest.